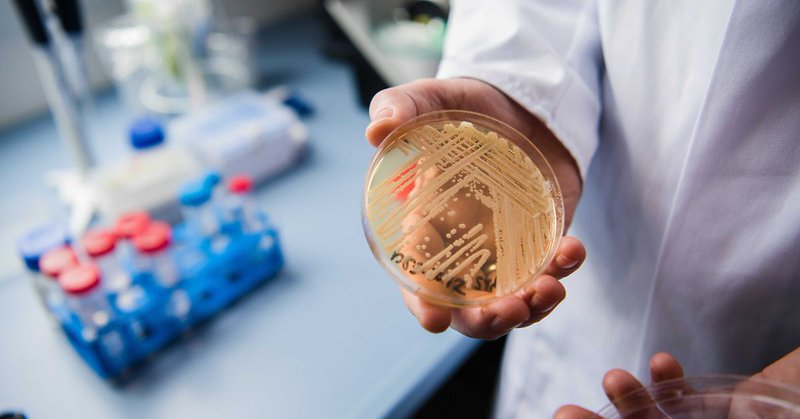
Tweet card summary image

Torben Hartmann
@hartmann_torben
Followers
4K
Following
101K
Media
3K
Statuses
66K
🇩🇪Ehemann, Vater, Denker, Optimist und daher #Habeck4Kanzler2029 Aufgeklärt, kritisch, geimpft. Be smart, #Maskup. Gegen die staatliche #Zwangsdurchseuchung
Schleswig-Holstein, Deutschlan
Joined August 2020
Wiederholte Covid Infektionen führen zu drastisch beschleunigter Verschlechterung bei Patienten mit interstitiellen Lungen Erkrankungen! @DieTechniker @BARMER_Presse @DAKGesundheit @StormAndreas @AOKRH @Buerger_Berlin @BKKDV @ikk_ev @pkv_verband @StartupVerband @BPI_Pharma
Führen wiederholte Covid Infektionen bei Patienten mit Vorerkrankungen zur Verschlechterung derselben? Bei interstitielle Lungenerkrankungen ist die Antwort: JA, sehr deutlich sogar Hier geht's zur Studie...➡️
0
3
12
Unabhängiges Online-Medienangebot DMZ braucht Unterstützung Die DMZ, ein unabhängiges Online-Medienangebot, steht aktuell vor einer finanziellen Herausforderung: Die neue Rechnung für Domain und Hosting ist da und beläuft sich auf 700 Euro.
1
16
13
Ansteckung per Schmierinfektion: Ein tödlicher Pilz nistet sich in Europas Krankenhäusern ein
n-tv.de
Candidozyma auris ist hochansteckend und überlebt sehr lange. Der Pilz ist in Europa angekommen und breitet sich inzwischen auch in deutschen Krankenhäusern aus. Gegen viele Anti-Pilz-Mittel ist er...
17
17
34
"Haben Testungen begonnen": Bundeswehr will mehrere Einheiten für Kamikaze-Drohnen aufstellen
n-tv.de
Drohnen sind im Krieg in der Ukraine allgegenwärtig. Die Bundeswehr hingegen hätte in diesem Bereich bei einem Angriff Russlands so gut wie nichts entgegenzusetzen. In den nächsten Jahren will man...
18
13
45
Heute Termin HNO. Doch kein Pilz im Ohr. Kein resistenter Keim laut Abstrich. Dafür jetzt das Problem im Mund. Wieder Tabletten. 😩 Ich war seit 10 Jahren nicht mehr so krank wie dieses Jahr. Arzt scheint übrigens Corona- Skeptiker zu sein -seinem Gesichtsausdruck zu urteilen...
10
2
67
Das ist treffend formuliert- wie immer. 🎯 #MerzKannNichtKanzler 🥳 #cducsuschadetdeutschland 🎪 #afdverbotsverfahrenjetzt 🚫
15
55
178
🇺🇦Russen zerstörten das Logistikzentrum einer großen Supermarktkette, die Tausende von Menschen mit Lebensmitteln versorgte. Vier Fahrer wurden dabei getötet. Und das passiert genau dann, wenn wir der Opfer des Holodomor gedenken. Die Russen ändern sich nie. 📍 Kiew 🇺🇦
Russians destroyed the logistics center of a major supermarket chain that fed thousands of people. They killed four drivers on the spot. And it happens right as we’re remembering the victims of the Holodomor. Russians never change. 📍Kyiv 🇺🇦 https://t.co/TeKrXWtlBw
117
207
555
😅
0
2
13
@ntvde Keine Macht für Faschisten, Hetzer und Verbrecher.
0
2
13
Hier sind vier Seiten aus „Männer, die die Welt verbrennen“ über die „#Familienunternehmer“ Das ist kein „Wirtschaftsverband“ (er fordert wirtschaftlich Unsinniges wie sehr teure Formen der Stromversorgung), sondern ein sehr ideologisch agierender Milliardärslobbyverband.
1
497
1K
Kritzelei, mit Symptomen, Stand 2017. Da war ich bereits einige Jahre krank. Gezeichnet, um in einer Klinik, nicht immer alles aufzählen zu müssen. Damals konnte ich mit Pausen noch ca. ½ Stunde langsam gehen. War sogar noch schwimmen. In der Klinik – übrigens eine Klinik für
1
15
49
"Und irgendwann hatte ich dann einen Patienten, der wollte was über #mecfs wissen. Und ich so, über WAS?! Und dann hab ich mir gedacht, das kann's doch nicht sein. Und dann hab ich mich halt eingelesen." Sagte die Internistin heute. Klingt doch gar nicht so schwer, oder?
3
12
146
Das wäre eine sinnvolle Aufgabe. 👍
@WithSpiders Rein theoretisch müsste man sich einmal die Mühe machen und die Krankheitszahlen von #TeamVorsicht und denen der Allgemeinbevölkerung vergleichen. Insbesondere, wenn man auf die aerosolübertragenden Krankheiten schaut. Die einen großen Einfluss auf das Krankheitsgeschehen haben.
0
1
12
Covid grillt Kinder Birnen Lt 96 klinischer Studien ist aber sicher mild, harmlos und wächst sich raus
96 studies on how Covid damages children’s brains. 96! Yet two different governments have minimised the impact of Covid in kids and they have neglected to put clean air mitigations in schools. It’s disgusting negligence! I hope certain MPs see prison for this one day.
1
37
127
@michael__3000 @PP_Stuttgart bitte ermitteln Sie zum darüber stehenden Tweet nach § 130 StGB. @Die_Gruenen @cem_oezdemir bitte zeigen Sie nach §§ 185, 187, 188 StGB an.
7
52
428
@Haselmaus2010 @ninawarken @BMG_Bund @kbv4u @BAEKaktuell @DoroBaer @c_drosten @hendrikstreeck Die Covidiotenländer 🇸🇪+ 🇬🇧 machen es uns vor. 1-2 Jahre danach schießen bei uns die Erkrankungszahlen in die Höhe. In den asiatischen Länder und denjenigen, wo massiv in Luftfilter investiert wurde, werden am wenigsten Kinder chronisch krank werden. Einfache Rechnung. 🤬
1
3
11
"Alle Rechtsmittel ausgeschöpft": Bolsonaro muss volle 27 Jahre in Haft
n-tv.de
Für den wegen eines Putschversuchs verurteilten Bolsonaro verlaufen die vergangenen Tage dramatisch. Am Samstag wird Brasiliens Ex-Präsident wegen Fluchtgefahr vom Hausarrest ins Gefängnis verlegt....
23
15
98